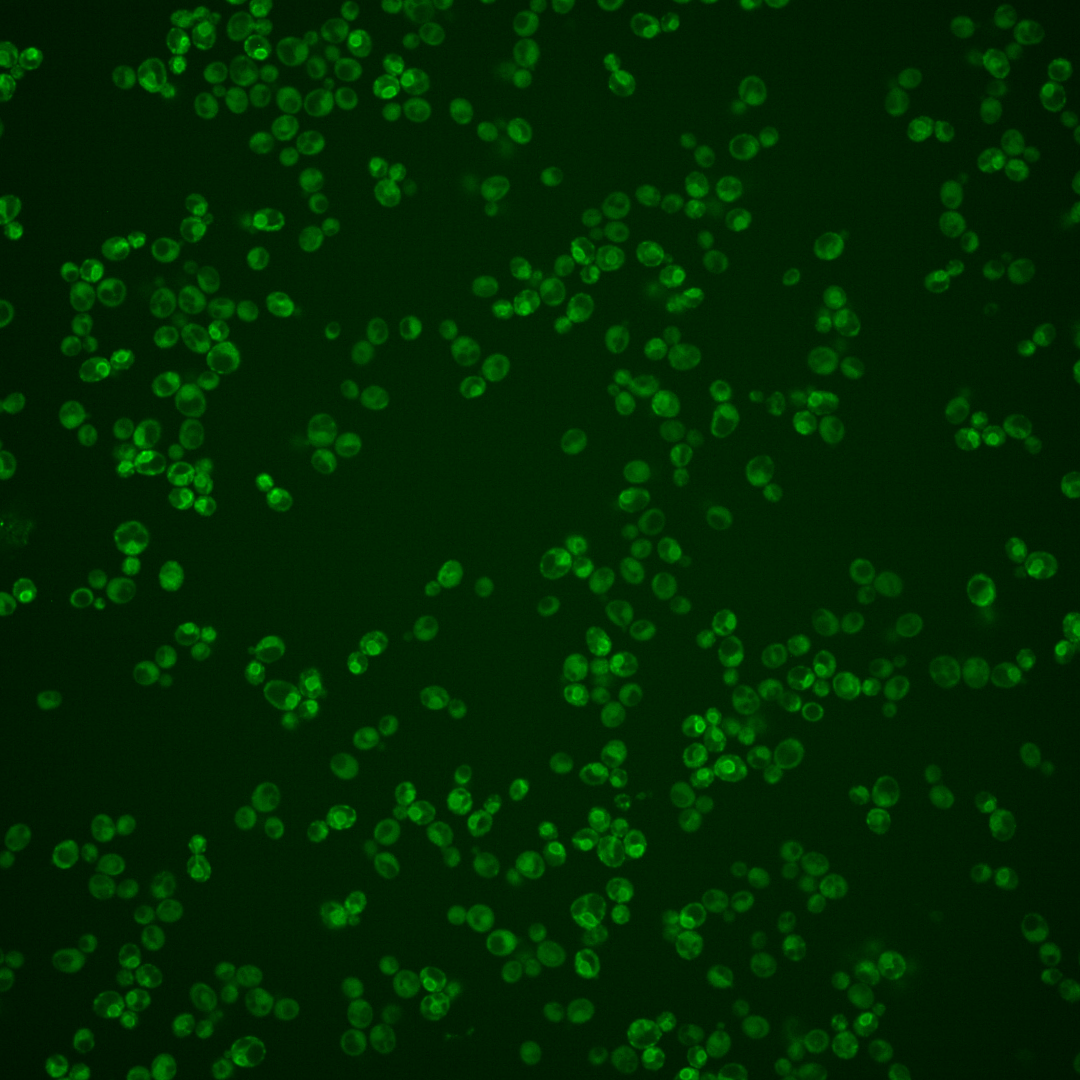
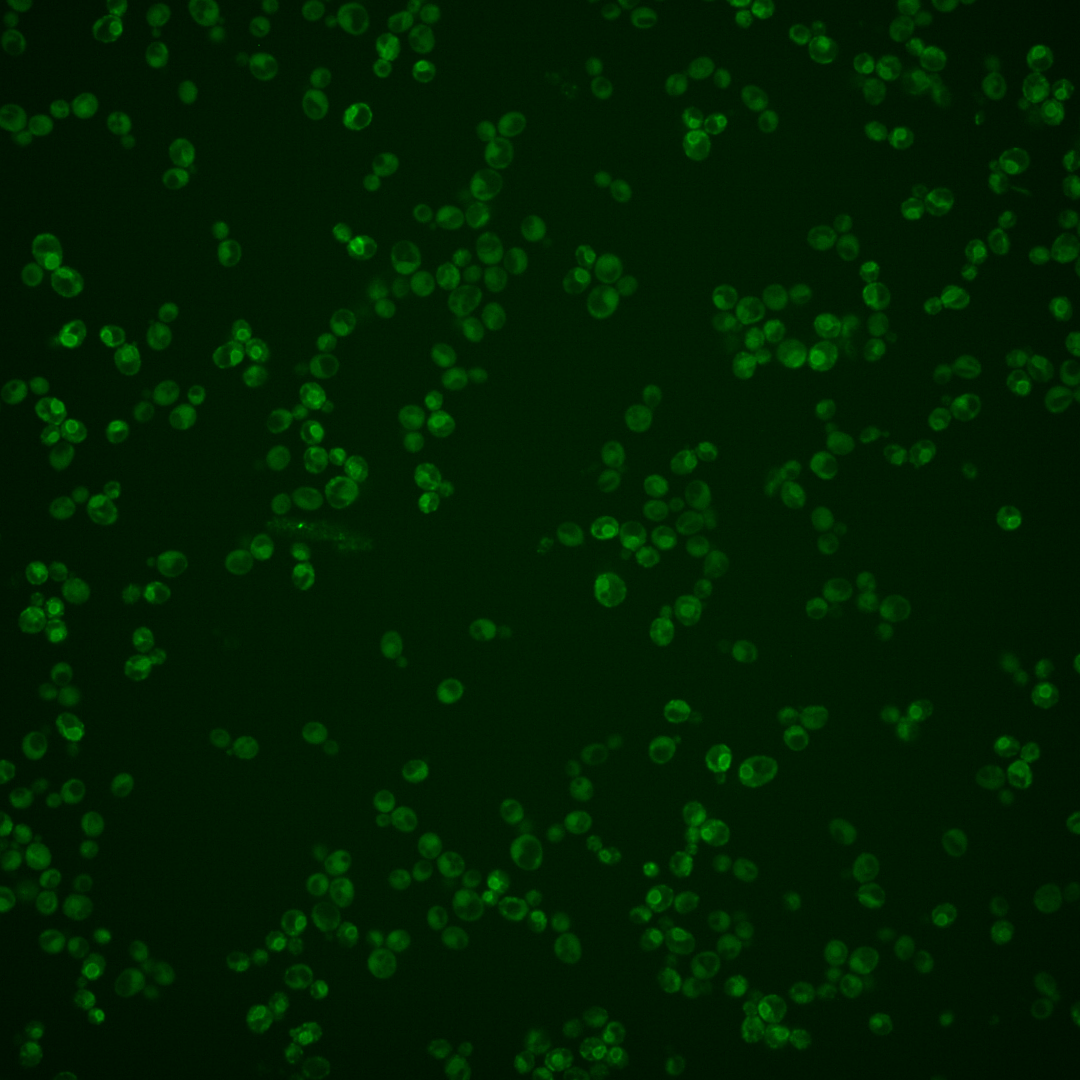
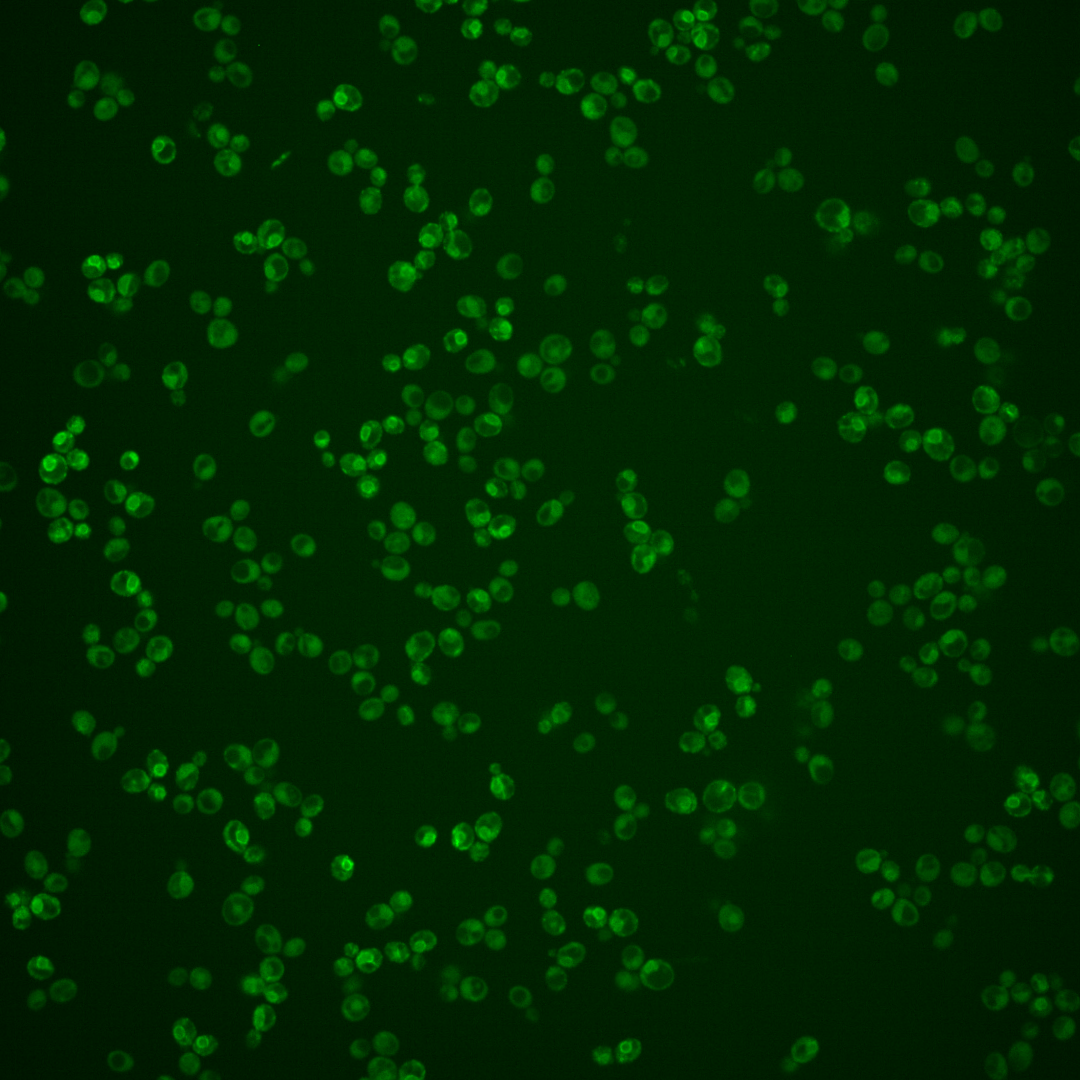
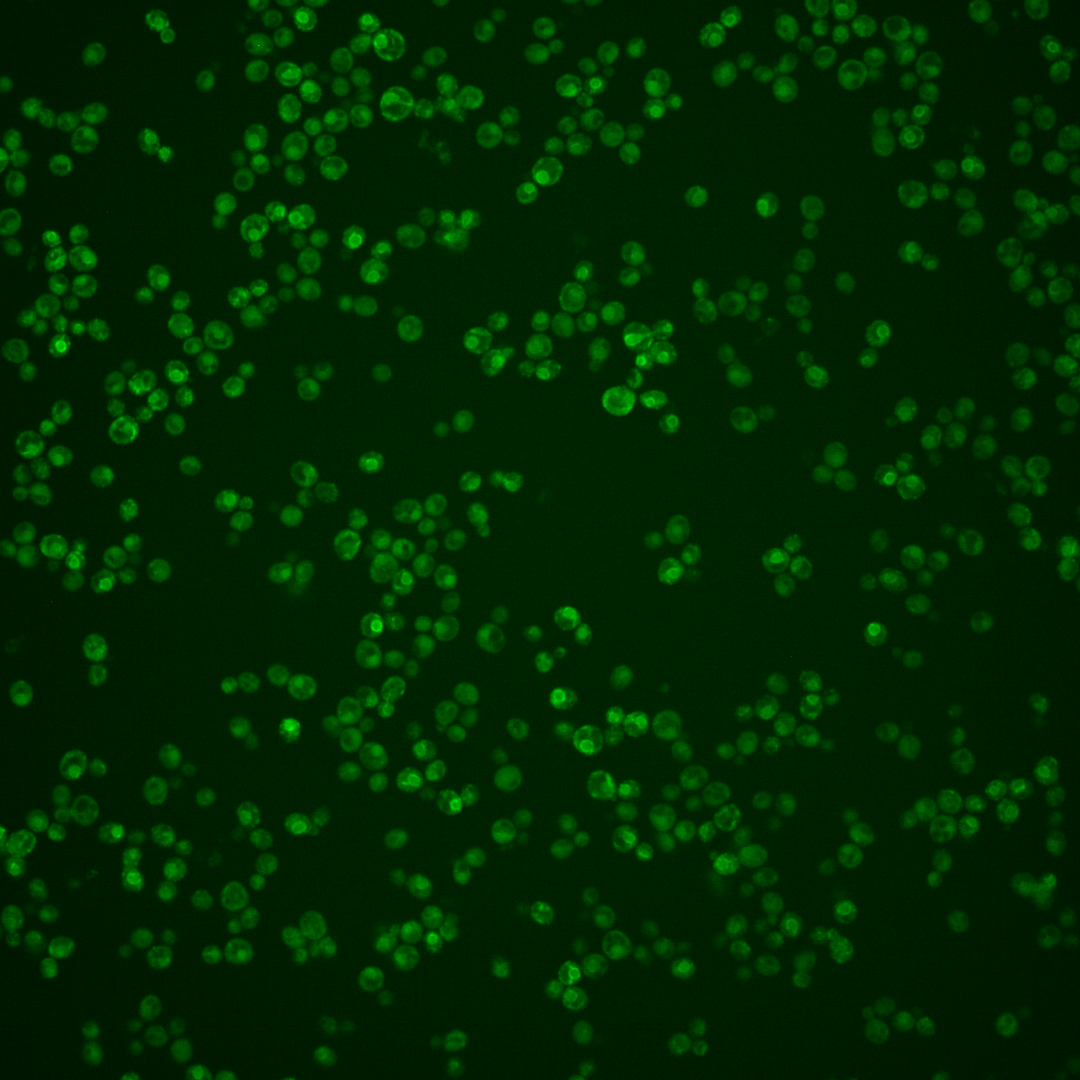
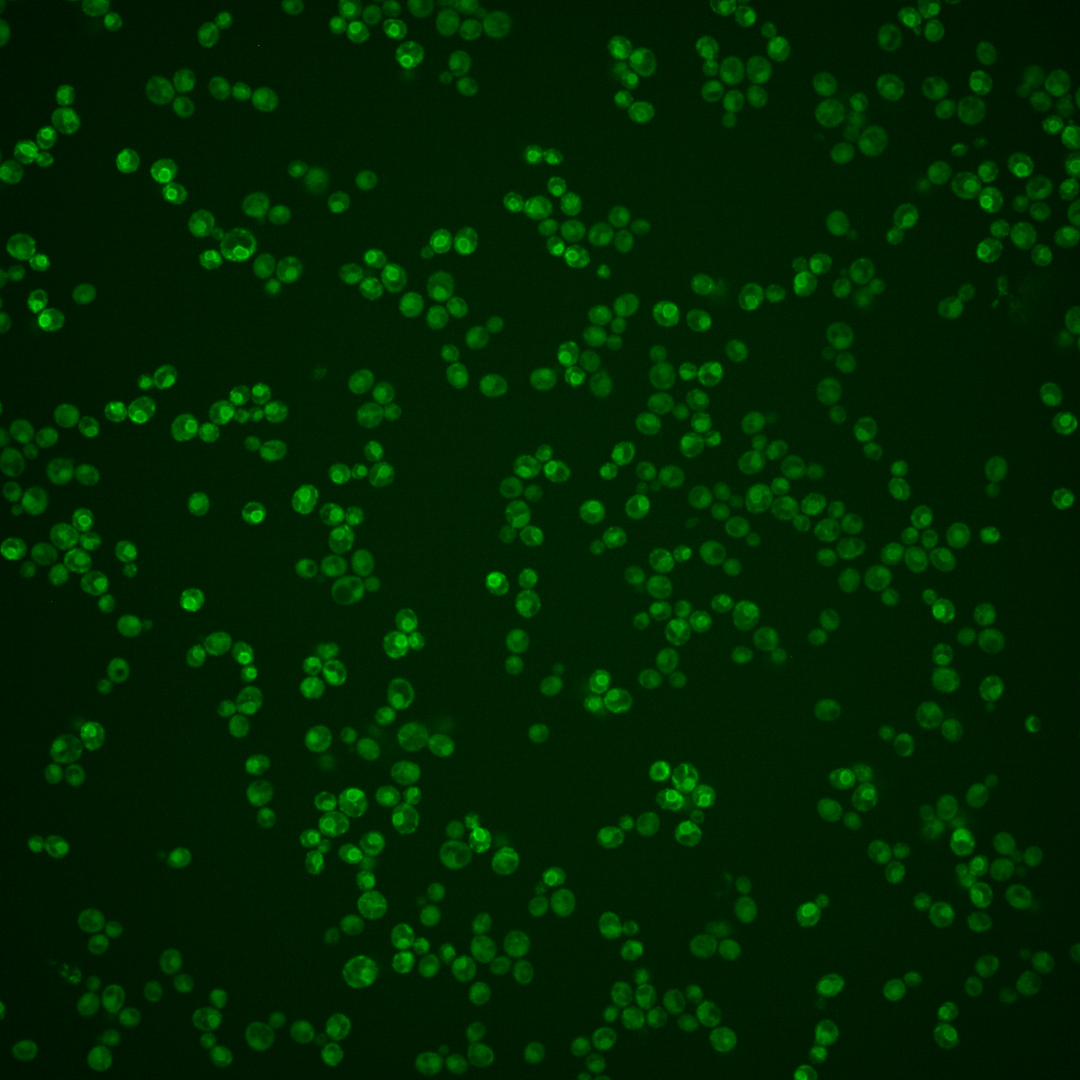

| Standard name | |
|---|---|
| Human Ortholog | |
| Description | Alpha 1,3 glucosyltransferase; involved in transfer of oligosaccharides from dolichyl pyrophosphate to asparagine residues of proteins during N-linked protein glycosylation; C998T transition in human ortholog ALG6 causes carbohydrate-deficient glycoprotein syndrome type-Ic; wild-type human ortholog ALG6 can partially complement yeast alg6 mutant |
Micrographs




















































































Sub-cellular Localization
Yeast GFP Assignment
Protein Abundance
Localization Change
External localization resources
| ensLOC | DeepLoc | |||||||||||||||||||||||
|---|---|---|---|---|---|---|---|---|---|---|---|---|---|---|---|---|---|---|---|---|---|---|---|---|
| Localization | WT1 | WT2 | WT3 | RAP60 | RAP140 | RAP220 | RAP300 | RAP380 | RAP460 | RAP540 | RAP620 | RAP700 | HU80 | HU120 | HU160 | rpd3Δ_1 | rpd3Δ_2 | rpd3Δ_3 | WT1 | WT2 | WT3 | AF100 | AF140 | AF180 |
| Cortical Patches | 1 | 3 | 13 | 1 | 2 | 3 | 4 | 10 | 7 | 10 | 5 | 5 | 11 | 12 | 6 | 16 | 17 | 12 | 5 | 7 | 14 | 7 | 8 | 9 |
| Bud | 2 | 0 | 3 | 4 | 1 | 5 | 9 | 5 | 6 | 12 | 0 | 11 | 0 | 1 | 0 | 4 | 0 | 2 | 3 | 12 | 10 | 4 | 4 | 16 |
| Bud Neck | 0 | 0 | 0 | 0 | 0 | 0 | 1 | 1 | 0 | 3 | 0 | 0 | 0 | 0 | 0 | 0 | 0 | 0 | 2 | 2 | 2 | 0 | 1 | 3 |
| Bud Site | 0 | 0 | 0 | 0 | 0 | 0 | 0 | 1 | 1 | 2 | 0 | 0 | 0 | 0 | 0 | 0 | 0 | 0 | – | – | – | – | – | – |
| Cell Periphery | 1 | 1 | 1 | 7 | 8 | 5 | 2 | 6 | 12 | 13 | 6 | 11 | 13 | 25 | 25 | 18 | 16 | 15 | 2 | 0 | 2 | 0 | 0 | 0 |
| Cytoplasm | 103 | 98 | 115 | 81 | 69 | 72 | 95 | 115 | 87 | 98 | 35 | 59 | 120 | 152 | 173 | 87 | 48 | 32 | 50 | 35 | 47 | 44 | 39 | 41 |
| Endoplasmic Reticulum | 24 | 107 | 128 | 66 | 36 | 33 | 96 | 66 | 68 | 131 | 34 | 37 | 140 | 147 | 143 | 12 | 3 | 4 | 172 | 166 | 166 | 125 | 105 | 103 |
| Endosome | 15 | 8 | 0 | 3 | 9 | 6 | 4 | 5 | 0 | 0 | 0 | 0 | 2 | 2 | 1 | 22 | 6 | 3 | 4 | 6 | 3 | 5 | 4 | 1 |
| Golgi | 0 | 3 | 1 | 2 | 2 | 0 | 1 | 1 | 0 | 0 | 0 | 0 | 1 | 3 | 2 | 2 | 13 | 1 | 5 | 2 | 5 | 4 | 0 | 1 |
| Mitochondria | 46 | 7 | 36 | 47 | 49 | 138 | 188 | 149 | 191 | 243 | 108 | 124 | 9 | 6 | 4 | 26 | 15 | 14 | 27 | 25 | 51 | 20 | 23 | 9 |
| Nucleus | 1 | 0 | 1 | 0 | 0 | 2 | 2 | 4 | 0 | 1 | 1 | 1 | 0 | 0 | 1 | 1 | 2 | 0 | 0 | 0 | 0 | 0 | 0 | 0 |
| Nuclear Periphery | 6 | 7 | 14 | 5 | 5 | 4 | 16 | 7 | 9 | 21 | 4 | 8 | 9 | 12 | 8 | 1 | 0 | 0 | 6 | 12 | 9 | 3 | 1 | 2 |
| Nucleolus | 0 | 0 | 0 | 0 | 1 | 0 | 0 | 1 | 0 | 0 | 0 | 0 | 0 | 0 | 1 | 0 | 0 | 0 | 0 | 0 | 0 | 0 | 0 | 0 |
| Peroxisomes | 1 | 0 | 0 | 0 | 0 | 0 | 0 | 0 | 0 | 0 | 0 | 0 | 0 | 0 | 1 | 5 | 3 | 3 | 0 | 0 | 1 | 0 | 1 | 0 |
| SpindlePole | 0 | 0 | 1 | 0 | 0 | 0 | 4 | 1 | 2 | 0 | 1 | 1 | 0 | 1 | 1 | 4 | 3 | 2 | 3 | 3 | 5 | 1 | 2 | 2 |
| Vac/Vac Membrane | 79 | 54 | 21 | 13 | 27 | 44 | 36 | 40 | 20 | 31 | 11 | 18 | 8 | 18 | 21 | 49 | 64 | 50 | 6 | 12 | 9 | 5 | 8 | 12 |
| Unique Cell Count | 237 | 253 | 286 | 201 | 175 | 236 | 350 | 325 | 308 | 415 | 158 | 203 | 275 | 334 | 349 | 214 | 171 | 109 | 296 | 293 | 337 | 224 | 209 | 211 |
| Labelled Cell Count | 279 | 288 | 334 | 229 | 209 | 312 | 458 | 412 | 403 | 565 | 205 | 275 | 313 | 379 | 387 | 247 | 190 | 138 | 296 | 293 | 337 | 224 | 209 | 211 |
Yeast GFP Assignment
Protein Abundance
| Screen | WT1 | WT2 | WT3 | RAP60 | RAP140 | RAP220 | RAP300 | RAP380 | RAP460 | RAP540 | RAP620 | RAP700 | HU80 | HU120 | HU160 | rpd3Δ_1 | rpd3Δ_2 | rpd3Δ_3 | AF100 | AF140 | AF180 |
|---|---|---|---|---|---|---|---|---|---|---|---|---|---|---|---|---|---|---|---|---|---|
| Mean Cell GFP Intensity (1e-4) | 6.0 | 7.2 | 5.8 | 5.5 | 6.2 | 5.2 | 4.8 | 5.0 | 4.9 | 5.0 | 4.8 | 5.0 | 6.9 | 6.7 | 6.6 | 7.2 | 8.7 | 8.7 | 6.4 | 6.6 | 7.5 |
| Std Deviation (1e-4) | 2.4 | 2.5 | 2.0 | 2.0 | 2.2 | 1.9 | 1.7 | 1.9 | 1.9 | 1.7 | 1.7 | 1.8 | 2.4 | 2.4 | 2.3 | 1.3 | 1.5 | 1.3 | 2.1 | 2.4 | 2.5 |
| Intensity Change (Log2) | – | – | – | -0.08 | 0.09 | -0.16 | -0.28 | -0.22 | -0.25 | -0.22 | -0.28 | -0.21 | 0.25 | 0.2 | 0.18 | 0.3 | 0.57 | 0.58 | 0.13 | 0.18 | 0.36 |
Localization Change
| Localization | RAP60 | RAP140 | RAP220 | RAP300 | RAP380 | RAP460 | RAP540 | RAP620 | RAP700 | HU80 | HU120 | HU160 | rpd3Δ_1 | rpd3Δ_2 | rpd3Δ_3 |
|---|---|---|---|---|---|---|---|---|---|---|---|---|---|---|---|
| Cortical Patches | -2.6 | -2.0 | -2.2 | 0 | -1.0 | -1.5 | -1.6 | 0 | -1.2 | -0.3 | -0.6 | -2.1 | 1.4 | 2.3 | 2.4 |
| Bud | 0 | 0 | 0 | 0 | 0 | 0 | 1.7 | 0 | 2.9 | 0 | 0 | 0 | 0 | 0 | 0 |
| Bud Neck | 0 | 0 | 0 | 0 | 0 | 0 | 0 | 0 | 0 | 0 | 0 | 0 | 0 | 0 | 0 |
| Bud Site | 0 | 0 | 0 | 0 | 0 | 0 | 0 | 0 | 0 | 0 | 0 | 0 | 0 | 0 | 0 |
| Cell Periphery | 0 | 0 | 0 | 0 | 0 | 3.0 | 2.6 | 0 | 0 | 3.3 | 4.4 | 4.3 | 4.7 | 4.9 | 0 |
| Cytoplasm | 0 | -0.2 | -2.3 | -3.5 | -1.2 | -3.1 | -4.7 | -3.9 | -2.5 | 0.8 | 1.3 | 2.4 | 0.1 | -2.6 | -2.0 |
| Endoplasmic Reticulum | -2.6 | -5.3 | -7.6 | 0 | -6.5 | -5.9 | -3.6 | 0 | -6.1 | 1.5 | -0.2 | -1.0 | -9.6 | -9.8 | -7.7 |
| Endosome | 0 | 0 | 0 | 0 | 0 | 0 | 0 | 0 | 0 | 0 | 0 | 0 | 5.5 | 0 | 0 |
| Golgi | 0 | 0 | 0 | 0 | 0 | 0 | 0 | 0 | 0 | 0 | 0 | 0 | 0 | 4.4 | 0 |
| Mitochondria | 3.1 | 4.1 | 11.1 | 0 | 8.9 | 12.4 | 12.2 | 0 | 11.3 | -4.1 | -5.3 | -5.9 | -0.1 | -1.3 | 0.1 |
| Nucleus | 0 | 0 | 0 | 0 | 0 | 0 | 0 | 0 | 0 | 0 | 0 | 0 | 0 | 0 | 0 |
| Nuclear Periphery | -1.4 | -1.1 | -2.0 | 0 | -1.9 | -1.2 | 0.1 | 0 | -0.5 | -1.0 | -0.8 | -1.8 | -2.9 | -2.9 | 0 |
| Nucleolus | 0 | 0 | 0 | 0 | 0 | 0 | 0 | 0 | 0 | 0 | 0 | 0 | 0 | 0 | 0 |
| Peroxisomes | 0 | 0 | 0 | 0 | 0 | 0 | 0 | 0 | 0 | 0 | 0 | 0 | 0 | 0 | 0 |
| SpindlePole | 0 | 0 | 0 | 0 | 0 | 0 | 0 | 0 | 0 | 0 | 0 | 0 | 0 | 0 | 0 |
| Vacuole | -0.4 | 2.8 | 3.9 | 1.3 | 2.0 | -0.4 | 0.1 | -0.1 | 0.6 | -2.4 | -1.0 | -0.7 | 5.0 | 8.0 | 8.9 |
External localization resources
Images






























Protein Concentration and Protein Localization Data
| R1 | R2 | R3 | ||||||||||||||||
|---|---|---|---|---|---|---|---|---|---|---|---|---|---|---|---|---|---|---|
| G1 Pre-START | G1 Post-START | S/G2 | Metaphase | Anaphase | Telophase | G1 Pre-START | G1 Post-START | S/G2 | Metaphase | Anaphase | Telophase | G1 Pre-START | G1 Post-START | S/G2 | Metaphase | Anaphase | Telophase | |
| Concentration | 2.6713 | 3.0632 | 2.9687 | 2.5925 | 1.8509 | 2.7316 | 3.8059 | 2.3786 | 2.4339 | 1.8263 | 2.0302 | 2.2518 | 3.3209 | 3.4077 | 3.3706 | 3.713 | 3.0442 | 3.4012 |
| Actin | 0.0202 | 0.0055 | 0.0041 | 0.0006 | 0.0006 | 0.002 | 0.107 | 0.007 | 0.0209 | 0.0057 | 0.0037 | 0.018 | 0.001 | 0.001 | 0.0037 | 0.0014 | 0.0003 | 0.0024 |
| Bud | 0.0002 | 0.0008 | 0.0004 | 0.0001 | 0.0032 | 0.0001 | 0.0019 | 0.0006 | 0.0005 | 0.0001 | 0.0001 | 0.0011 | 0.0002 | 0.0014 | 0.0006 | 0.0002 | 0 | 0.0009 |
| Bud Neck | 0.0013 | 0.0003 | 0.0039 | 0.0018 | 0.0001 | 0.0023 | 0.0052 | 0.0004 | 0.007 | 0.0004 | 0.0002 | 0.0009 | 0.0002 | 0.0009 | 0.0004 | 0.0012 | 0.0003 | 0.001 |
| Bud Periphery | 0.0003 | 0.0012 | 0.001 | 0.0002 | 0.0098 | 0.0004 | 0.0065 | 0.003 | 0.0009 | 0.0002 | 0.0002 | 0.0052 | 0.0003 | 0.0018 | 0.0016 | 0.0009 | 0.0001 | 0.0012 |
| Bud Site | 0.0013 | 0.0023 | 0.0013 | 0.0005 | 0.0002 | 0.0006 | 0.0211 | 0.0053 | 0.0087 | 0.0003 | 0.0003 | 0.0004 | 0.0043 | 0.0088 | 0.002 | 0.0001 | 0.0002 | 0.0002 |
| Cell Periphery | 0.0006 | 0.0011 | 0.0008 | 0.0003 | 0.0006 | 0.0006 | 0.0023 | 0.0013 | 0.001 | 0.0007 | 0.0002 | 0.0006 | 0.0008 | 0.0009 | 0.0011 | 0.0006 | 0.0002 | 0.0005 |
| Cytoplasm | 0.1803 | 0.2652 | 0.1577 | 0.1216 | 0.1728 | 0.2094 | 0.0721 | 0.1234 | 0.1198 | 0.0709 | 0.1354 | 0.1728 | 0.107 | 0.1572 | 0.1639 | 0.1463 | 0.1046 | 0.1829 |
| Cytoplasmic Foci | 0.0254 | 0.0225 | 0.0111 | 0.0158 | 0.0059 | 0.0155 | 0.0478 | 0.0249 | 0.0275 | 0.006 | 0.0214 | 0.0093 | 0.009 | 0.0092 | 0.0105 | 0.0061 | 0.0042 | 0.0109 |
| Eisosomes | 0.0005 | 0.0002 | 0.0002 | 0.0002 | 0.0001 | 0.0002 | 0.0016 | 0.0005 | 0.0004 | 0.0005 | 0.0002 | 0.0002 | 0.0003 | 0.0003 | 0.0005 | 0.0003 | 0.0001 | 0.0002 |
| Endoplasmic Reticulum | 0.2545 | 0.1971 | 0.2847 | 0.2795 | 0.0623 | 0.2564 | 0.2553 | 0.2111 | 0.2485 | 0.3066 | 0.0651 | 0.1838 | 0.3006 | 0.234 | 0.2518 | 0.2277 | 0.2082 | 0.2184 |
| Endosome | 0.0198 | 0.0204 | 0.0148 | 0.0217 | 0.0026 | 0.0161 | 0.0656 | 0.0327 | 0.0296 | 0.015 | 0.0336 | 0.0163 | 0.0152 | 0.031 | 0.0189 | 0.0177 | 0.0058 | 0.0158 |
| Golgi | 0.0043 | 0.0019 | 0.0015 | 0.0008 | 0.0003 | 0.002 | 0.0259 | 0.0039 | 0.0107 | 0.0012 | 0.0174 | 0.0088 | 0.0006 | 0.0013 | 0.0014 | 0.0008 | 0.0002 | 0.0008 |
| Lipid Particles | 0.0141 | 0.0105 | 0.0043 | 0.0076 | 0.0008 | 0.0076 | 0.0216 | 0.0121 | 0.0247 | 0.01 | 0.0387 | 0.0031 | 0.0079 | 0.01 | 0.0096 | 0.0047 | 0.0011 | 0.0049 |
| Mitochondria | 0.0018 | 0.0007 | 0.0009 | 0.0007 | 0.0009 | 0.0081 | 0.0116 | 0.006 | 0.0043 | 0.0016 | 0.0191 | 0.0052 | 0.0007 | 0.0031 | 0.0028 | 0.0017 | 0.0003 | 0.0014 |
| None | 0.3871 | 0.4375 | 0.4597 | 0.4936 | 0.6722 | 0.4389 | 0.2331 | 0.5314 | 0.4458 | 0.5596 | 0.5752 | 0.5301 | 0.499 | 0.4788 | 0.4573 | 0.5111 | 0.6373 | 0.4999 |
| Nuclear Periphery | 0.0534 | 0.0193 | 0.0338 | 0.0369 | 0.0491 | 0.0226 | 0.0626 | 0.0148 | 0.014 | 0.0138 | 0.0066 | 0.0278 | 0.0398 | 0.0336 | 0.0507 | 0.051 | 0.0283 | 0.0371 |
| Nucleolus | 0.0005 | 0.0004 | 0.0004 | 0.0002 | 0.0002 | 0.0007 | 0.0017 | 0.0007 | 0.0005 | 0.0002 | 0.0002 | 0.0003 | 0.0003 | 0.0008 | 0.0006 | 0.0005 | 0.0002 | 0.0004 |
| Nucleus | 0.0087 | 0.0045 | 0.0048 | 0.0069 | 0.0139 | 0.0051 | 0.0092 | 0.0026 | 0.0027 | 0.0016 | 0.0011 | 0.0061 | 0.0041 | 0.0107 | 0.0079 | 0.0157 | 0.0029 | 0.0065 |
| Peroxisomes | 0.015 | 0.0003 | 0.0008 | 0.0007 | 0.0002 | 0.001 | 0.0135 | 0.0005 | 0.0185 | 0.0003 | 0.0757 | 0.0012 | 0.0002 | 0.0004 | 0.0005 | 0.0004 | 0.0001 | 0.0004 |
| Punctate Nuclear | 0.0034 | 0.0024 | 0.0027 | 0.0014 | 0.0006 | 0.0034 | 0.014 | 0.0027 | 0.0079 | 0.0012 | 0.0015 | 0.0038 | 0.0019 | 0.0027 | 0.0041 | 0.0034 | 0.0021 | 0.0062 |
| Vacuole | 0.0051 | 0.0054 | 0.0091 | 0.0072 | 0.0027 | 0.0056 | 0.0145 | 0.014 | 0.0046 | 0.0033 | 0.003 | 0.0037 | 0.0051 | 0.0101 | 0.0075 | 0.006 | 0.003 | 0.0061 |
| Vacuole Periphery | 0.002 | 0.0007 | 0.002 | 0.0017 | 0.0008 | 0.0013 | 0.0061 | 0.0012 | 0.0014 | 0.0009 | 0.0013 | 0.0012 | 0.0014 | 0.0021 | 0.0028 | 0.0023 | 0.0006 | 0.0018 |
Sequencing Data
| R1 | R2 | |||||||||
|---|---|---|---|---|---|---|---|---|---|---|
| G1 Post-START | S/G2 | Metaphase | Anaphase | Telophase | G1 Post-START | S/G2 | Metaphase | Anaphase | Telophase | |
| Gene Expression | 43.8662 | 32.5776 | 37.6039 | 48.7774 | 35.8747 | 34.3991 | 47.5788 | 46.7277 | 41.4763 | 54.8234 |
| Translational Efficiency | 0.5696 | 0.6062 | 0.59 | 0.4397 | 0.52 | 0.7973 | 0.5018 | 0.5388 | 0.6454 | 0.4956 |
Hit Data
| Dataset | Hit |
|---|---|
| Protein Concentration | ✘ |
| Protein Localization | ✘ |
| Gene Expression | ✘ |
| Translational Efficiency | ✘ |
Endocytosis
| Temp | Actin Patch (Sac6-tdTomato) | Cortical Patch (Sla1-GFP) | Late Endosome (Snf7-GFP) | Vacuole (Vph1-GFP) |
|---|---|---|---|---|
| 37℃ | ||||
| RT |
Cell Cycle Omics
CYCLoPs (Alg6-GFP)
| Gene / Allele | Actin Patch (Sac6-tdTomato) | Cortical Patch (Sla1-GFP) | Late Endosome (Snf7-GFP) | Vacuole (Sac6-tdTomato) |
|---|
| Gene | Images |
|---|
| Gene | Images |
|---|
Images are not yet available
Images are not yet available